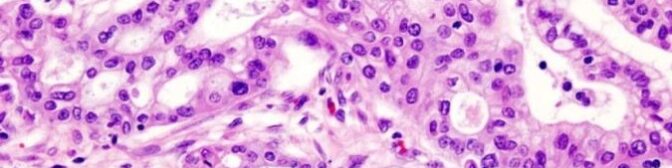

Cientistas do Instituto de Pesquisa do Câncer, em Londres, identificaram uma molécula que ajuda a transformar células cancerígenas do pâncreas potencialmente tratáveis em uma forma mais agressiva da doença. O estudo, publicado na revista Nature, poderá abrir caminhos para o tratamento de um dos tumores mais letais em todo o mundo, a sétima causa de morte por câncer no Brasil.Os pesquisadores demonstraram que a chamada Grem1 é uma peça essencial no mecanismo que permite às células doentes se espalharem e crescerem no organismo. No estudo, feito com roedores, foi possível manipular os níveis da proteína, revertendo a capacidade das estruturas cancerígenas se transformarem num subtipo mais agressivo, responsável por 90% dos casos de tumor de pâncreas. Os tratamentos disponíveis, hoje, são pouco eficazes, com menos de 5% de sobrevida em cinco anos.”O diagnóstico da grande maioria dos casos de tumor no pâncreas é feito tardiamente, com a doença já avançada, e até mesmo disseminada aos gânglios linfáticos e a outros órgãos. Por isso se torna inoperável e não mais passível de cura”, destaca a oncologista Mirian Cristina da Silva, da Oncoclínicas Brasília. Segundo os pesquisadores britânicos, justamente por evitar essa disseminação, a manipulação da Grem1 poderá levar ao desenvolvimento de novas drogas, caso o efeito seja replicado em humanos.
Sem metástase
Os cientistas fizeram testes tanto em camundongos quanto em organoides — complexos celulares que reproduzem a função de um órgão (no caso, o pâncreas). Ao desligar o gene que regula a Grem1, as células tumorais tornaram-se invasivas e, em 10 dias, se transformaram no subtipo letal, espalhando-se por outros tecidos. Em 90% dos roedores com Grem1 não ativa, o câncer chegou também ao fígado. Já naqueles com níveis normais da proteína, o percentual foi de 15%.Os pesquisadores, então, demonstraram que aumentar os níveis de Grem1 pode evitar a agressividade do câncer de pâncreas, reduzindo também o risco de metástase. Além disso, eles descobriram que outra proteína, chamada BMP2, está envolvida na regulação da primeira, sugerindo que, juntas, elas são responsáveis pelo comportamento das células de câncer de pâncreas.Embora reconheçam que o estudo está em estágio inicial, os pesquisadores mostraram-se animados com as descobertas, que precisam ser confirmadas e testadas diversas vezes, até que um tratamento seja possível. “Mostramos que é possível regredir os tumores agressivos para um estado que os torna mais fáceis de tratar. Ao entender melhor o que impulsiona a disseminação agressiva do câncer de pâncreas, esperamos, agora, explorar esse conhecimento e identificar maneiras de tornar a doença menos agressiva e mais tratável”, disse o autor sênior do estudo, Axel Behrens, que lidera a equipe de células-tronco do instituto britânico.Para a oncologista Mirian Cristina da Silva, o trabalho é promissor: “Apesar de os dados serem preliminares, nos trazem caminhos para novas vias de regulação do crescimento e diferenciação do câncer de pâncreas”.Fonte: Correio Braziliense